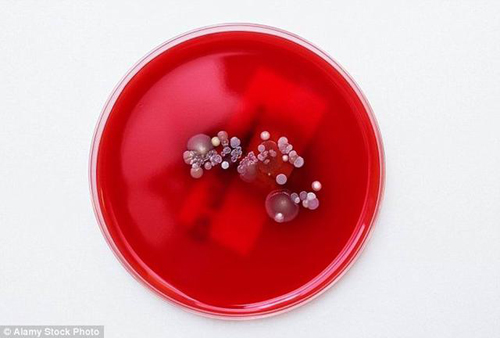
1468374603765008183.jpg 136329222.jpg

科学家实验表明未来可使用细菌对手机充电
来源:腾讯科学 日期:2016-07-13
据英国每日邮报报道,通常人们是不会喜欢细菌的,它们爬行在食物上,或者寄生在家中,但目前科学家最新研究表明,未来细菌将帮助我们对手机充电。
科学家模拟实验显示,细菌的自然运动产生动能可以采集利用,作为微型“风力发电厂”。他们认为,细菌也可以对智能手机充电。这项技术可在微型等级产生能量,如果得以广泛应用,将具有深远意义,有助于解决人类日益增长的能量危机。
英国牛津大学研究人员使用计算机模拟证实细菌作为一种密集活跃物质,通过组织利用可使圆柱形转子运行,可以提供一种稳定的动力源。他们指出,生物驱动发电站未来有一天将成为微型发动机,适用于自组装和自供电的小型人造电设备,例如:智能手机或者麦克风。
牛津大学物理系泰勒-申德鲁克(TylerShendruk)博士说:“生产千兆瓦级电能具有一定的挑战,发现和有效利用微观等级发电也有一定难度。一种潜在的方法是对微型机械提供少量动能,直接在细菌悬液采集能量。”目前这项最新研究报告发表在近期出版的《科学》杂志上。
密集细菌悬液是一种典型的活性液体,该液体流动方式是自然的。虽然游动中的细菌能够群游,驱动无序液体流动,但它们通常过于混乱无序,难以提取任何有用的能量形式。目前研究人员将64个微型转子构成的一个晶格放入细菌悬液,发现细菌能够自发地组织在一起,使邻近转子开始以相反方向旋转,这让人们联想到一种简单结构的风力发电装置。
申德鲁克博士解释称,令人吃惊的是,我们没有预设计微型齿轮状涡轮,这些转子能够自组装成一种细菌风力发电装置。当我们在细菌湍流中的一个单个转子,它被随机地“踢开”,当我们在细菌悬液中放置一批转子时,它们会突然形成一种规律性模式,同时邻近转子会以相反的方向旋转。
研究报告合著作者、阿敏-多斯特莫哈马迪(AminDoostmohammadi)博士称,从生物系统获得少量机械能量是非常宝贵的,因为它并不需要输入功率,仅使用内部生物化学过程来实现移动。
著名学者朱莉娅-约曼斯(JuliaYeomans)教授强调称,自然界是非常神奇的,能够制造微型发动机,如果我们深入理解和分析,它们将具有巨大的潜能。(悠悠/编译)